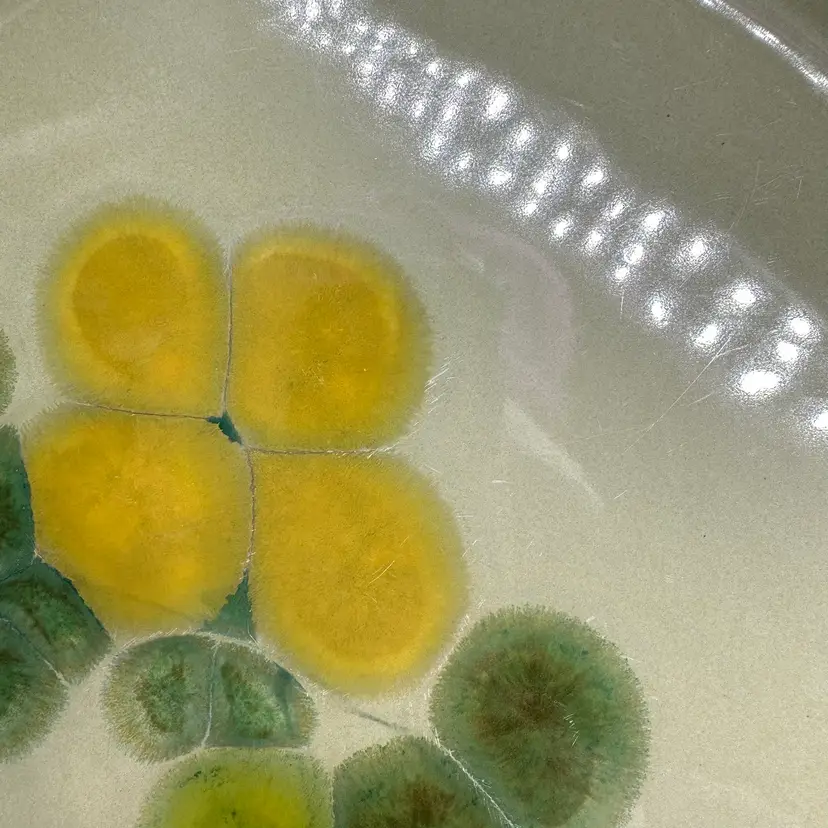

Franciscan Pebble Beach Avocado Green Dinner Plate 10.5”
Details
This large dinner plate is made by Franciscan Earthenware in the style “Pebble Beach”. These plates can be bought as a set of 8, or purchased separately. Each plate includes a “Franciscan Earthware” stamp on the bottom and measures approximately 10.5” across. There are no chips or cracks present on any plate, however, slight utensil marks are detected. The worst of the markings are pictured for two of the plates. The rest have slightly any utensil markings to none. These plates are oven safe.
133 Views
Meet Your Seller
Selling since October 2023
You can call me Jocelyn, but social media knows me as Crazy Lamp Lady. I've dabbled in antiques and collectibles for fourteen years, but my favorite things to sell are glass and pottery. I'm really excited to be the founder of Niknax--I hope you enjoy browsing for your next treasure!
Report Listing
Report Listing